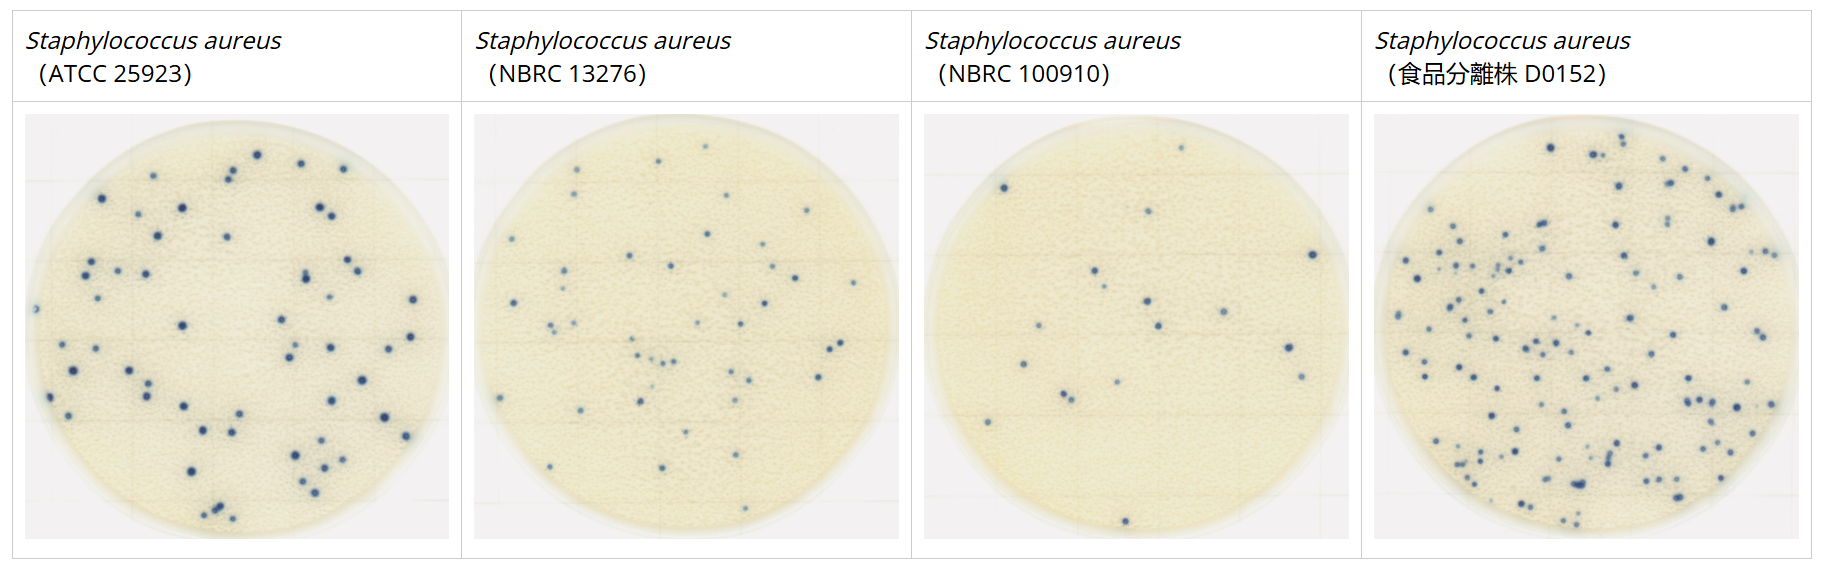
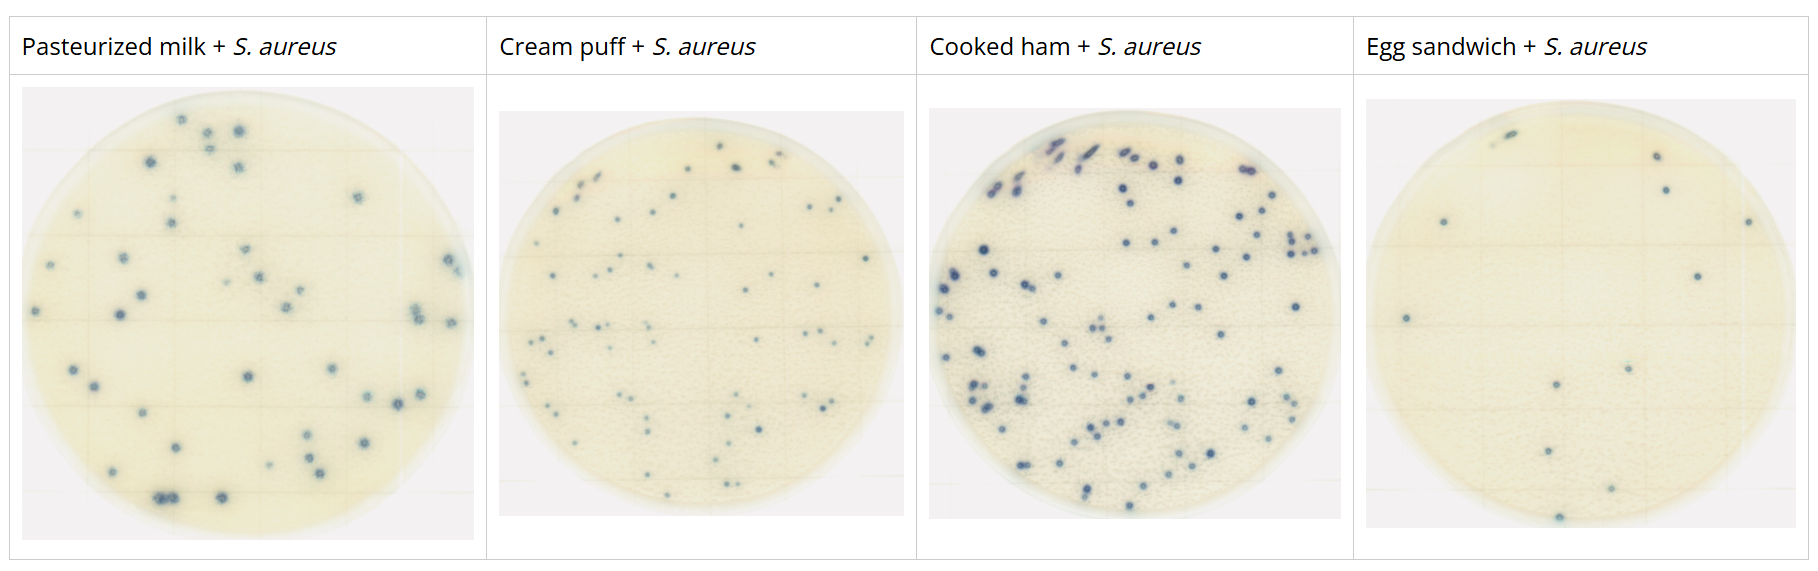

Description
Easy Plate SA is a custom media formulation that has been certified by AOAC PTM and MicroVal for cultivating Staphylococcus aureus. It is a microbial test kit that includes a chromogenic substrate, which produces vividly coloured blue colonies that are easily distinguishable, enabling convenient identification and quantification of Staphylococcus aureus. Unlike Baird-Parker agar and Mannitol salt agar with egg yolk, which require 48 hours of incubation, Easy Plate SA significantly reduces the incubation time to approximately 24±1 hours. Additionally, Easy Plate SA contains inhibitors that restrict the growth of non-Staphylococcus aureus bacteria, but if they do grow, the resulting colonies will exhibit a distinctive pink to red-violet colour, facilitating clear differentiation. The certification of Easy Plate SA by AOAC PTM and MicroVal ensures its quality, and it is available in packages of 100 tests, divided into four separate bags, each containing 25 tests. When stored unopened at temperatures between 2-8℃, Easy Plate SA maintains its effectiveness for up to 12 months.
Features
1. Easy to distinguish bright-coloured colonies in just 24 hours
- Identifying is simpler in comparison to agar count media due to the colour change, eliminating the need for confirming the egg-yolk reaction.
- Incubation time is halved from 48 hours to 24 hours
- The use of Easy Plate only requires a single sheet, whereas the surface plating method typically needs three or more plates.
2. Highly Specific
- Easy Plate can detect certain strains of S. aureus that display negative egg yolk reactions on traditional agar media.
- Selective media inhibits numerous bacteria besides S. aureus. However, if any non-Staph aureus colonies do grow, their pink to red-violet colouration makes them easy to identify.
3. High correlation with the plate count agar
High correlation with the plate count agar in various foods. According to the research by DNP.
Colouring
Identifying and counting S. aureus colonies becomes effortless as they display a distinct blue colouration when they develop. SA Easy Plate media effectively inhibits the growth of other bacteria. However, if any other bacteria do grow, they should exhibit a noticeable pink to red-violet colouration, simplifying discrimination.
Example
Strains
Foods
Product Specifications
| Packaging | 100 tests (25 tests x 4 bags) |
| Object Microorganism | Staphylococcus aureus |
| Incubation Times | 24 ± 1 hours |
| Incubation Temperature | 35 or 37 ± 1℃ |
| Storage Condition (Unopened) | 2 – 8℃ |
| Storage Condition (After opened) | After opening the package, fold the open end of the package at least 2 times and tape it. Store in a refrigerator (2 to 8°C) and use within 3 months. |
| Shelf life | 12 months after manufacturing date |
| Certification/Regulation | Certified by AOAC RI PTM, MicroVal, & NordVal |
For automated Easy Plate Colony Counting click here to view our Scanner!

Exportable Data and Reports for Regulatory Compliance


See how A3 technology finds what ATP technology can’t


